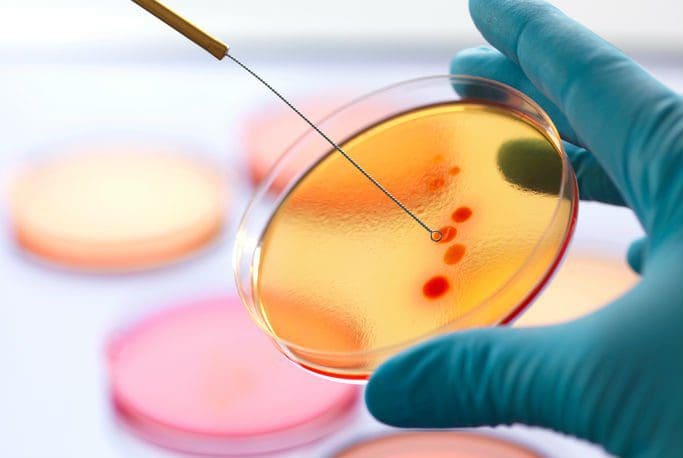

Успей подать декларацию: расширен график работы Управления налогового учета

2023-03-22 18:24:38https://rupor.md/uspej-podat-deklaracziyu-rasshiren-grafik-raboty-upravleniya-nalogovogo-ucheta/
Депутат ПДС: Россия пытается превратить Молдову во вторую Беларусь

2023-03-22 18:00:57https://rupor.md/deputat-pds-rossiya-pytaetsya-prevratit-moldovu-vo-vtoruyu-belarus/
«Взятие пленных, стрельба, подрыв мостов». Молдавский легионер рассказал о своей деятельности в Украине
2023-03-22 17:25:48https://rupor.md/vzyatie-plennyh-strelba-podryv-mostov-moldavskij-legioner-rasskazal-o-svoej-deyatelnosti-v-ukraine/
Пополнить санкционный список: какие доводы приводят молдавские власти?

2023-03-22 17:52:33https://rupor.md/popolnit-sankczionnyj-spisok-kakie-dovody-privodyat-moldavskie-vlasti/
Парламент Швеции одобрил вступление страны в НАТО: дебаты длились шесть часов

2023-03-22 17:10:03https://rupor.md/parlament-shveczii-odobril-vstuplenie-strany-v-nato-debaty-dlilis-shest-chasov/
(ФОТО) Программа на 2023 год: модернизация 30 населенных пунктов Оргеевского района

2023-03-22 15:00:47https://rupor.md/foto-programma-na-2023-god-modernizacziya-30-naselennyh-punktov-orgeevskogo-rajona/
(ФОТО) Обучение специалистов по Программе улучшения отношений для разлученных родителей

2023-03-22 16:15:23https://rupor.md/foto-obuchenie-speczialistov-po-programme-uluchsheniya-otnoshenij-dlya-razluchennyh-roditelej/
Санду промульгировала закон о замене синтагмы «молдавский язык»

2023-03-22 15:54:54https://rupor.md/sandu-promulgirovala-zakon-o-zamene-sintagmy-moldavskij-yazyk/
Новая напасть: в США тревожными темпами распространятся опасная инфекция
2023-03-22 15:37:13https://rupor.md/novaya-napast-v-ssha-trevozhnymi-tempami-rasprostranyatsya-opasnaya-infekcziya/
Бывший акционер Air Moldova лоукостер Blue Air объявил о банкротстве

2023-03-22 14:54:25https://rupor.md/byvshij-akczioner-air-moldova-loukoster-blue-air-obyavil-o-bankrotstve/



